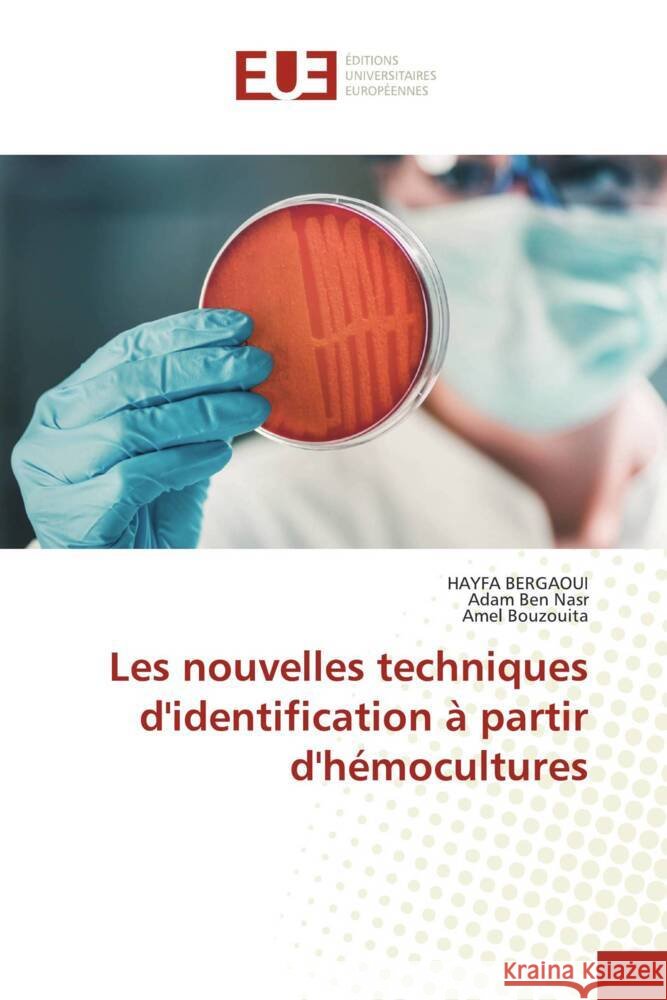
Les nouvelles techniques d'identification ? partir d'h?mocultures Hayfa Bergaoui Adam Be Amel Bouzouita 9786206709022

Wyniki wyszukiwania:
wyszukanych pozycji: 35
|
Les nouvelles techniques d'identification ? partir d'h?mocultures
ISBN: 9786206709022 / Francuski Termin realizacji zamówienia: ok. 10-14 dni roboczych. |
cena:
276,89 |
 |
Cancro da vulva
ISBN: 9786207600274 / Portugalski Termin realizacji zamówienia: ok. 10-14 dni roboczych. |
cena:
276,89 |
 |
Prise en charge d'une Primipare ?g?e: Grossesse Et Accouchement
ISBN: 9786206712084 / Francuski Termin realizacji zamówienia: ok. 10-14 dni roboczych. |
cena:
199,59 |
 |
Carcinome Lobulaire Infiltrant Du Sein
ISBN: 9786206696780 / Francuski Termin realizacji zamówienia: ok. 10-14 dni roboczych. |
cena:
313,26 |
 |
D?pistage Du Portage G?nital Du Streptocoque B Au Troisi?me Trimestre
ISBN: 9786206706052 / Francuski Termin realizacji zamówienia: ok. 10-14 dni roboczych. |
cena:
199,59 |
 |
Cancer de la vulve
ISBN: 9786206702238 / Francuski Termin realizacji zamówienia: ok. 10-14 dni roboczych. |
cena:
276,89 |
 |
Betreuung einer älteren Primipare: SCHWANGERSCHAFT UND GEBURTSTAGE
ISBN: 9786208081607 / Niemiecki / Miękka / 2024 / 56 str. Termin realizacji zamówienia: ok. 10-14 dni roboczych. Die Häufigkeit von Erstschwangerschaften nach dem 38. Lebensjahr nimmt in Tunesien stetig zu und das Durchschnittsalter der Erstgeburt liegt mittlerweile bei 40 Jahren. Ziel: Das Profil der Erstgebärenden über 38 Jahre zu identifizieren und die mütterlichen, fetalen und geburtshilflichen Komplikationen zu ermitteln. Material und Methoden: Wir haben eine retrospektive Studie (2021/2022) mit 50 Fällen durchgeführt, die in der Abteilung für Gynäkologie und Geburtshilfe des Zentrums für Geburtshilfe und Neonatologie in Monastir durchgeführt wurde. Ergebnisse. Die Häufigkeit betrug 0,58...
Die Häufigkeit von Erstschwangerschaften nach dem 38. Lebensjahr nimmt in Tunesien stetig zu und das Durchschnittsalter der Erstgeburt liegt mittlerw...
|
cena:
199,59 |
 |
Gestão de uma primípara idosa: GRAVIDEZ E PARTO
ISBN: 9786208081645 / Portugalski / Miękka / 2024 / 56 str. Termin realizacji zamówienia: ok. 10-14 dni roboczych. |
cena:
199,59 |
 |
Gestione di una primipara anziana: GRAVIDANZA E PARTO
ISBN: 9786208081638 / Włoski / Miękka / 2024 / 56 str. Termin realizacji zamówienia: ok. 10-14 dni roboczych. |
cena:
199,59 |
 |
MISOPROSTOL DANS LA MATURATION CERVICALE
ISBN: 9786206723738 / Francuski / Miękka / 2024 / 72 str. Termin realizacji zamówienia: ok. 10-14 dni roboczych. La rupture prématurée des membranes est une situation obstétricale fréquente. Elle touche 8 à 10% des grossesses à terme.Sa PEC optimale est controversé. Parmi les moyens utilisés dans la maturation cervicale: les prostaglandines, dont la Dinoprostone qui en est la molécule de référence.Matériel et méthodes Il s'agit d'un essai clinique prospectif, randomisé réalisé au centre de maternité et de néonatologie du CHU de Monastir sur une période de 1 année (janvier-décembre 2017). Incluant 240 parturientes présentant une RPM à terme et reparties en 2 groupes: Le groupe...
La rupture prématurée des membranes est une situation obstétricale fréquente. Elle touche 8 à 10% des grossesses à terme.Sa PEC optimale est con...
|
cena:
199,59 |
 |
MISOPROSTOL IN CERVICAL RIPENING
ISBN: 9786208229641 / Angielski / Miękka / 2024 / 52 str. Termin realizacji zamówienia: ok. 10-14 dni roboczych. Premature rupture of the membranes is a frequent obstetrical condition. It affects 8 to 10% of full-term pregnancies, and its optimal management is controversial. Among the agents used to promote cervical ripening are prostaglandins, of which Dinoprostone is the reference molecule.Material and methods This is a prospective, randomized clinical trial conducted at the maternity and neonatology center of Monastir University Hospital over a period of 1 year (January-December 2017).Including 240 parturients presenting with RPM at term and divided into 2 groups:The "oral route" group: having...
Premature rupture of the membranes is a frequent obstetrical condition. It affects 8 to 10% of full-term pregnancies, and its optimal management is co...
|
cena:
199,59 |
 |
LOBULÄRES INFILTRIERENDES KARZINOM DER BRUST
ISBN: 9786208081843 / Niemiecki / Miękka / 2024 / 84 str. Termin realizacji zamówienia: ok. 10-14 dni roboczych. Das lobuläre infiltrierende Karzinom (CLI) der Brust ist eine seltene histologische Entität mit einer Häufigkeit zwischen 5 und 15% aller Brustkrebserkrankungen.Es wird als zweithäufigster histologischer Typ eingestuft, nach dem unspezifischen infiltranten Krebs (NISC). Die Ziele unserer Arbeit bestanden darin, die klinisch-anatomischen Besonderheiten sowie die therapeutischen Modalitäten zu beschreiben, den Stellenwert der Brustbildgebung bei der positiven Diagnose zu präzisieren und die wichtigsten prognostischen Faktoren herauszuarbeiten.Wir haben eine deskriptive retrospektive...
Das lobuläre infiltrierende Karzinom (CLI) der Brust ist eine seltene histologische Entität mit einer Häufigkeit zwischen 5 und 15% aller Brustkreb...
|
cena:
313,26 |
 |
MISOPROSTOL NA MATURAÇÃO DO COLO DO ÚTERO
ISBN: 9786208229726 / Portugalski / Miękka / 2024 / 52 str. Termin realizacji zamówienia: ok. 10-14 dni roboczych. |
cena:
199,59 |
 |
INFILTRATING LOBULAR CARCINOMA OF THE BREAST
ISBN: 9786208081850 / Angielski / Miękka / 2024 / 80 str. Termin realizacji zamówienia: ok. 10-14 dni roboczych. Infiltrating lobular carcinoma (ILC) of the breast is a rare histological entity, accounting for between 5% and 15% of all breast cancers.It is classified as the second most frequent histological type, after non-specific infiltrating cancer (NIC). The aims of our work were to describe the anatomo-clinical particularities and therapeutic modalities, to specify the role of breast imaging in the positive diagnosis and to identify the main prognostic factors.We carried out a retrospective descriptive study of 30 observations of CLI of the breast collected in the Obstetrics and Gynaecology...
Infiltrating lobular carcinoma (ILC) of the breast is a rare histological entity, accounting for between 5% and 15% of all breast cancers.It is classi...
|
cena:
313,26 |
 |
Management of elderly primiparous women: PREGNANCY AND DELIVERY
ISBN: 9786208081614 / Angielski / Miękka / 2024 / 56 str. Termin realizacji zamówienia: ok. 10-14 dni roboczych. The frequency of first pregnancies after the age of 38 is increasing steadily in Tunisia and the average age of first childbirth is now 40. Aim: To identify the profile of primiparous women over 38 years of age and the maternal, foetal and obstetric complications. Materials and Methods: We conducted a retrospective study in 2021/2022 of 50 cases in the obstetrics and gynaecology department of the Monastir maternity and neonatology centre. Results. The frequency was 0.58%, complications such as arterial hypertension, gestational diabetes, premature rupture of membranes, placenta previa and...
The frequency of first pregnancies after the age of 38 is increasing steadily in Tunisia and the average age of first childbirth is now 40. Aim: To id...
|
cena:
199,59 |
 |
MISOPROSTOL IN DER ZERVIXREIFUNG
ISBN: 9786208229672 / Niemiecki / Miękka / 2024 / 52 str. Termin realizacji zamówienia: ok. 10-14 dni roboczych. Der vorzeitige Blasensprung ist eine häufige geburtshilfliche Situation. Er betrifft 8-10% der Terminschwangerschaften, seine optimale Behandlung ist umstritten und es werden u.a. Prostaglandine, darunter Dinoproston als Referenzmolekül, zur zervikalen Reifung eingesetzt.Material und Methoden Es handelt sich um eine prospektive, randomisierte klinische Studie, die über einen Zeitraum von einem Jahr (Januar-Dezember 2017) im Zentrum für Geburtshilfe und Neonatologie des Universitätsklinikums Monastir durchgeführt wurde.Die Studie umfasste 240 Gebärende mit PMR am Termin, die in zwei...
Der vorzeitige Blasensprung ist eine häufige geburtshilfliche Situation. Er betrifft 8-10% der Terminschwangerschaften, seine optimale Behandlung ist...
|
cena:
199,59 |
 |
MISOPROSTOLO NELLA MATURAZIONE CERVICALE
ISBN: 9786208229733 / Włoski / Miękka / 2024 / 52 str. Termin realizacji zamówienia: ok. 10-14 dni roboczych. |
cena:
199,59 |














